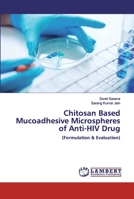
Chitosan Based Mucoadhesive Microspheres of Anti-HIV Drug 6202554746 Book Cover

- Python Interview Questions: Brush up for your next Python interview with 240+ solutions on most common challenging interview questions
- Business Process Re-Engineering - Post COVID-19
- C Programming and Coding Question Bank with Solution (2nd Edition): Make Your Coding Strong and Ready to Crack the Technical Interview
- Kotlin at a Glance
- C Programming and Coding Question Bank with Solutions